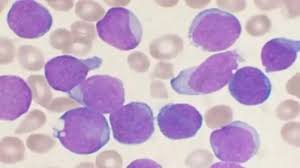

Today’s Current Affairs: 3rd April 2026 for UPSC IAS exams, State PSC exams, SSC CGL, State SSC, RRB, Railways, Banking Exam & IBPS, etc
Table of Contents
General Anti Avoidance Rules:

India has amended income tax rules and has clarified that gains arising from assets acquired before April 1, 2017, will remain outside the ambit of general anti-avoidance rules (GAAR).
- General Anti Avoidance Rules is an anti-tax avoidance law in India to curb tax evasion and avoid tax leaks.
- It came into effect in 2017. The GAAR provisions come under the Income Tax Act, 1961.
- It was recommended by the Parthasarathi Shome Committee
- It is specifically aimed at cutting revenue losses that happen to the government due to aggressive tax avoidance measures practiced by companies.
- GAAR is a tool for checking aggressive tax planning, especially those transactions or business arrangements that are entered into with the objective of avoiding tax.
- It is meant to apply to transactions that are prima facie legal, but result in tax reduction.
- GAAR applies only if the tax benefit exceeds ₹3 crore in a financial year.
- GAAR provisions give wide powers to tax authorities to treat any arrangement or a transaction as an ‘impermissible avoidance arrangement’ (IAA) and re-compute income and consequent tax implications.
Gangotri National Park:

The Gangotri National Park reopened after six-month winter break.
- It is located in Uttarakhand.
- It sits along the upper catchment of the Bhagirathi River.
- The northeastern section of the park forms the international boundary of India and Tibet (China).
- The area enclosed by the park also borders Kedarnath Wildlife Sanctuary and Govind National Park.
- The mountains in the park are part of the Gangotri Group of the Garhwal Himalayas, which are a subrange of the eastern Himalayas.
- Major peaks within the park include Chaukhamba I, Satopanth, Chaukhamba II, Chaukhamba III, and Kedarnath Main.
- The famous Gangotri Glacier is located in the park boundaries and is known for being one of the primary sources of the Ganges.
- Western Himalayan subalpine conifer forests dominate the lower elevation landscapes. These forests are filled with fir trees intermixed with deodar, oak, spruce, and rhododendrons trees.
- Higher elevations in the park are home to Western Himalayan alpine shrubs.
- It mainly home to Snow leopard, brown bear, blue sheep, musk deer, Asian black bear, and the Himalayan tahr etc.
Multi-Hazard Early Warning Decision Support System:

The Multi-Hazard Early Warning Decision Support System represents a decisive transformation in India’s approach to weather forecasting and disaster risk reduction.
- It is an advanced digital forecasting platform developed by the Indian Meteorological Department (IMD) using open-source technology and in-house expertise.
- It is digital transformation initiative under Mission Mausam.
- It was officially launched in 2024.
- It operates in real time using tools such as Geographic Information System (GIS) maps, enabling forecasters to quickly collect, analyse, and disseminate weather information in a clear and user-friendly manner.
- Over 90% of weather data collection, quality checks, and integration are automated, enabling faster detection of weather systems and their possible impacts.
- More than 95% of numerical weather prediction model inputs are used in forecasting, improving risk assessment for different weather hazards.
Re-engineered Forecasting System: The entire forecasting and warning generation process has been re-engineered, enabling real-time alerts and faster decision-making. - Forecast lead time has increased, allowing authorities and communities to prepare in advance.
- The time required to prepare forecasts has reduced, enabling quicker dissemination of warnings.
- Nodal Ministry: Ministry of Earth Sciences (MoES)
Newcastle Disease: In News

Reports of Newcastle disease circulating across Europe, poultry producers across the UK are being urged to step up vigilance as the virus continues its concerning westward spread.
- It is caused by avian paramyxovirus serotype 1, affects chickens and a wide range of other birds.
- It is a highly contagious and often severe disease found worldwide that affects birds including domestic poultry.
- The disease appears in three forms: lentogenic or mild, mesogenic or moderate and velogenic or very virulent.
- The lentogenic strains are very widespread but cause few disease outbreaks.
- Infected birds shed virus in exhaled air, respiratory discharge, and feces.
- It usually presents as a respiratory disease, but depression, nervous manifestations, or diarrhoea may be the predominant clinical form.
- Respiratory signs – gasping, coughing, sneezing and rales
- Nervous signs – tremors, paralyzed wings and legs, twisted necks, circling, spasms, and paralysis
- Apartial or complete drop in egg production may occur. Eggs may be abnormal in color, shape, or surface, and have watery albumen
- There is no treatment for Newcastle Disease, although treatment with antibiotics to control secondary infections may assist.
Earthquake Lights:

Small earthquakes shook parts of the Aegean Sea near Turkey and Greece and floating lights appear in the sky after earthquake near Turkey which is called as earthquake lights by the scientists.
- Earthquake lights are flashes, streaks, balls, or tall pillars of light that sometimes appear in the sky right before, during, or just after an earthquake.
- Earthquakes happen when huge tectonic plates push and grind against each other.
- This stress squeezes rocks in the crust, especially those containing quartz or certain minerals.
- The pressure creates electric charges inside the rocks.
- These charges then flow upward through cracks and faults until they reach the surface. Once there, they bump into air molecules and ionise them, stripping electrons and creating glowing plasma.
- The result is visible flashes or steady beams with no heat or fire.
- Scientists have noted that lights appear more often in places with straight, vertical faults, like rift zones, which act like easy pathways for electricity.
Trade Enablement and Marketing Initiative:

The Minister of State for Micro, Small and Medium Enterprises informed the Lok Sabha about the Trade Enablement and Marketing Initiative.
- It is a Central Sector Scheme under the Raising and Accelerating MSME Performance (RAMP) Programme.
- The initiative will empower MSMEs with digital tools and guidance to effectively utilize the e-commerce marketplace.
- The key objectives of the TEAM Initiative:
- Facilitating onboarding of MSMEs onto the ONDC network to enable digital commerce participation.
- Supporting MSMEs in creation of digital product catalogues, branding and packaging improvements.
- Providing training and capacity building on e-commerce operations, digital marketing, logistics and online payments.
- Strengthening market linkages and increasing online sales opportunities for participating enterprises.
- Duration: 3 years from 2024 to 2027.
- Eligibility Criteria: All the Udyam registered Micro and Small Enterprises (MSEs) under manufacturing and services sectors will be eligible for benefits under the Initiative.
- Targeted beneficiaries: It envisages benefiting 5 lakh Micro and Small Enterprises (MSEs) of which 50% are to be women owned MSEs.
- Implementing Agency: National Small Industries Corporation (NSIC)
- Nodal Ministry: It has been launched by the Ministry of Micro, Small and Medium Enterprises (MoMSME).
SAMPANN Platform:

The Goa government and the Cochin Port Authority have taken a significant step towards modernizing pension disbursement by signing agreements to onboard the SAMPANN digital platform.
- SAMPANN (System for Accounting and Management of Pension) is the flagship digital pension and financial management platform of the Department of Telecommunications.
- It is managed by the Office of the Controller General of Communication Accounts (CGCA).
- It was designed to streamline pension sanction, authorisation, accounting and payment through a single digital platform.
- It was launched in 2018.
- It provides direct credit of pension into the bank accounts of pensioners.
- It is a cloud-based, end-to-end pension management system of the Department of Telecommunications.
- Direct disbursement of pension on a timely basis without intermediaries
- Single window system for complete pension process
- Online grievance management for the pensioners, reducing paperwork
- Tracking of pension status from home encourages transparency and accountability
- Faster processing of arrears and revision of pension.
Non-Deliverable Derivative:

The Reserve Bank of India (RBI) gave directive to bar banks from Non-Deliverable Derivative (NDD) contracts in the rupee.
- An NDD is a derivative contract where two parties agree on a future exchange rate for the rupee, but settle the difference in cash, usually in US dollars.
- As India has capital controls, offshore investors can’t freely trade in the rupee in physical form. This led to the creation of the NDD markets in the rupee.
- The NDD market is widely used by foreign investors, hedge funds and global banks who cannot freely access and play in the Indian rupee market.
- These trades take place offshore, outside the control of the RBI.
- This often acts as a price discovery mechanism for the rupee, even influencing expectations before Indian markets open.
- These instruments have long been criticised for distorting price discovery.
- Some participants would cancel and re-enter contracts to take advantage of favourable movements, effectively turning hedging tools into speculative instruments.
Antariksh Venture Capital Fund:

The Union Minister said that India’s dedicated Antariksh venture capital fund for the space sector has progressed steadily, with investment in selected startups expected to begin from the first quarter of FY2027.
- Antariksh Venture Capital Fund is a close ended fund registered with the Securities and Exchange Board of India (SEBI) as a Category II Alternative Investment Fund (AIF).
- Indian National Space Promotion and Authorization Centre (IN-SPACe), Department of Space, Government of India.
- The Fund is sponsored by SIDBI Venture Capital Limited.
- The Fund’s investment objective is to provide much-needed capital to companies in the space sector at various stages of development as well as support the scaling of operations and the commercialization of new technologies, empowering the companies to contribute to India’s broader space ambitions.
- It is looking to invest exclusively in Indian companies operating in the Space sector with Technology Readiness Level (TRL) of 4 and above.
Indian National Space Promotion and Authorization Centre:
- It is a single-window, independent, nodal agency that functions as an autonomous agency in the Department of Space (DOS).
- It is formed following the Space sector reforms to enable and facilitate the participation of private players.
- It is responsible to promote, enable, authorize and supervise various space activities of non-governmental entities (NGEs) including building launch vehicles & satellites and providing space-based services; sharing space infrastructure and premises under the control of DOS/ISRO; and establishing of new space infrastructure and facilities.
- The agency acts as an interface between ISRO and NGEs and assesses how to utilize India’s space resources better and increase space-based activities.
- Three Directorates viz., Promotion Directorate (PD), Technical Directorate (TD) and Program Management and Authorization Directorate (PMAD) are carrying out the functions of IN-SPACe.
YUVIKA Programme:

The Union Minister of State (Independent Charge) for Science & Technology highlighted the Government’s sustained efforts to nurture scientific temper among the youth, stating that the Yuva Vigyani Karyakram (YUVIKA).
- YUva VIgyani KAryakram (YUVIKA) is a learning and awareness creating programme of the ISRO.
- It imparts basic knowledge on Space Technology, Space Science, and Space Applications to younger students with a preference to rural areas.
- The programme is aimed at creating awareness about the emerging trends in science and technology amongst the youngsters, who are the future building blocks of our nation.
- It is also expected to encourage more students to pursue Science, Technology, Engineering and Mathematics (STEM) based research /career.
- Those who have finished class 8 and are currently studying in class 9 can apply for the programme.
- Three students from each state/Union Territory will participate in this programme every year, covering CBSE, ICSE, and state-board syllabus.
- The selection is based on 8th Standard academic performance and extracurricular activities.
- Students belonging to the rural area have been given special weightage in the selection criteria.
- In case there is a tie between the selected candidates, the younger candidates will be given priority.
- This programme involves:
- It is a two-week residential programme offered by ISRO.
- It will include invited talks, experience sharing by eminent scientists, facility and lab visits, exclusive sessions for discussions with experts and practical and feedback sessions.
Ammonium Nitrate:

A leasing agreement was signed between Bharat Coal Gasification and Chemicals Limited (BCGCL) and Mahanadi Coalfields Limited (MCL) for the upcoming Coal to Ammonium Nitrate Project at Lakhanpur, Odisha.
- Ammonium nitrate (NH4NO3) is a crystal-like white solid which is made in large industrial quantities.
- It is a salt of ammonia and nitric acid.
- Properties of Ammonium Nitrate:
- It has a melting point of 170°C.
- It is highly soluble in water; heating of the water solution decomposes the salt to nitrous oxide (laughing gas).
- It is commonly used in agriculture as a high-nitrogen fertilizer, and it has also been used as an oxidizing agent in explosives.
- It is one of the base ingredients used in the manufacture of commercial explosives.
- It is the main component of slurry explosives used for mining.
- Legal Controls on Ammonium Nitrate in India
-
- Under rules introduced in 2012 and updated in 2021, any mixture containing over 45% ammonium nitrate is legally classified as an explosive.
- A District Magistrate may permit possession of up to 30 metric tonnes, while larger quantities need approval from the Petroleum and Explosives Safety Organisation (PESO).
- PESO issues licences for the manufacture, storage, transport, and use of large quantities of ammonium nitrate.
Rice’s Whale:

Scientists fear that USA administration’s plan to expand oil drilling in Gulf of Mexico will push Rice’s Whales to extinction.
- Rice’s whales are members of the baleen whale family Balaenopteridae.
- These are most closely related to Bryde’s whales.
- In 2021, the Rice’s whale was recognized as a new species, evolutionarily distinct from other Bryde’s whales around the world.
- They have three prominent ridges in front of their blowhole. Their body is sleek, and their pectoral fins are slender and pointed.
- Rice’s whales are uniformly dark gray on top with a pale to pink belly.
- It is the only whale species that lives year-round in the Gulf of America.
- They are mainly dependent on silver-rag driftfish.
- Threats: Vessel strikes, noise pollution, oil spills, and climate change.
- Conservation Status
- IUCN Red List: Critically Endangered
Samrat Samprati:

The Prime Minister of India inaugurated the Samrat Samprati Museum in Gujarat.
- Samrat Samprati (224-215 BC) was a Mauryan ruler.
- He was the grandson of Samrat Ashoka.
- He was known as Indrapalit, Sangat and Vigatashok.
- He was known for propagating Jainism and the principle of non-violence.
- His life is described in Jain scripture like ‘Sampratikatha’, ‘Parishistaparva’, and ‘Prabhavakcharita’.
- King Samprati had established centres of Jain culture in Iran and in Arab countries.
- It is said that Samprati, also known as ‘Jain Ashoka’,built thousands of Jain temples in western and southern India.
- Jainism is a sramanic religion. Sramana’ is a Sanskrit word that denotes an ascetic or monk.
- Jainism is one of the religions whose origin can be traced back to the twenty four teachers (tirthankaras – ones who establishes a path or ford), through whom their faith is believed to have been handed down.
- The 24th Tirthankara was Vardhamana Mahavira.
- Jainism mainly aims at the attainment of liberation. It can be attained through three principles required to be observed to attain Moksha/Nirvana
- Samyakdarshana: Right Faith
- Samyakjnana: Right Knowledge
- Samyakcharita: Right Action
- The five doctrines of Jainism (five vows), known as Panchamahavratas, are for the monks.
- Ahimsa: do not commit violence
- Satya:do not tell a lie
- Asteya: do not steal
- Aparigraha: do not hoard
- Brahmacharya: observe continence.
E20 Fuel:

The Central government has implemented a new fuel mandate for petrol pumps to supply E20 fuel with a minimum octane rating of 95 RON.
- E20 Fuel is a blend of 20 per cent ethanol and 80 per cent petrol.
- Ethanol is a biofuel derived from crops such as sugarcane, maize, and grains.
- It offers a higher octane rating and potentially cleaner combustion, making it a more advanced alternative.
- While regular petrol in India typically has an octane rating of around 91 to 92 RON, E20 fuel comes with a minimum rating of 95 RON.
- This higher octane helps in smoother combustion.
- Ethanol, also known as ethyl alcohol, is a type of alcohol that is commonly used in various applications.
- It is a clear, colourless liquid with a characteristic odour and taste.
- Ethanol has the chemical formula C2H5OH and is composed of carbon, hydrogen, and oxygen atoms.
- Pure ethanol is nontoxic and biodegradable, and if spilled, they break down into harmless substances.
- However, fuel ethanol contains denaturants to make fuel ethanol undrinkable.
- Ethanol can be produced from various sources, but it is often derived from renewable resources such as crops like corn, sugarcane, barley, and wheat.
- It can also be produced from cellulosic materials like agricultural residues and wood.
Acute Lymphoblastic Leukaemia: Study
The multi-institutional study of 830 adult ALL patients treated at eight academic centres between found that about one in 10 adults diagnosed with Acute lymphoblastic leukaemia (ALL ) had a mutation in TP53.
- Acute lymphoblastic leukaemia or acute lymphocytic leukaemia is a type of blood cancer that affects the white blood cells and bone marrow.
- It is a fast-growing cancer. It is the most common type of paediatric cancer.
- Bleeding from the gums, Bone pain, Fever, Frequent infections and Frequent or severe nosebleeds etc.
- It occurs when a bone marrow cell develops changes (mutations) in its genetic material or DNA.
- Types of Acute Lymphoblastic Leukaemia: The World Health Organization classifies acute lymphoblastic leukemia into two main groups:
- B-cell lymphoblastic leukemia/lymphoma: Starts in immature cells that ordinarily develop into B-cell lymphocytes. B-cell ALL is the most common subtype.
- T-cell lymphoblastic leukemia: Starts in immature cells that ordinarily develop into T-cell lymphocytes. T-cell ALL is less common.
- Treatment: It may include chemotherapy or targeted drugs that specifically kill cancer cells.
7th round of Foreign Office Consultations between India and Algeria:

The 7th round of Foreign Office Consultations between India and Algeria was held in Algiers.
- Algeria is located in the Maghreb region of North Africa.
- It is bordered by seven countries namely Tunisia, Libya, and Niger to the northeast, east, and southeast respectively; Mali, Mauritania, and Western Sahara lie to the southwest. Morocco borders to the west
- It has a coastline on the Mediterranean Sea to the north.
- Capital City: Algiers
- Geographical Features of Algeria:
- Climate: It mainly consists of Mediterranean climate, with warm, dry summers and mild, rainy winters.
- Major Rivers: Djedi River and Chelif River
- Highest Point: Mount Tahat
- Mountain Ranges: Mountain ranges in Algeria include the Atlas mountains, the Saharan Atlas, the Tell Atlas, the Hoggar Mountains, and the Tassili n’ Ajjer mountains.
- Natural Resources: It has abundant natural resources including oil, gas, solar energy, iron, zinc, lead, silicon, and helium.
Snowy owl:

The snowy owl has been designated for international protection by the U.N. Convention on the Conservation of Migratory Species of Wild Animals.
- The Snowy owl (Bubo scandiacus) is a large, white owl of the true owl family.
- It is mainly live in the Arctic in open, treeless areas called tundra.
- It can also be found in coastal dunes and prairies, open moorland, meadows, marshes, and agricultural areas.
- It is native to Arctic regions in North America and Eurasia.
- Unlike many other owls, Snowy owls are not nocturnal, and can be seen hunting any time of the day or night.
- It is a nomadic bird, rarely breeding at the same locations or with the same mates on an annual basis and often not breeding at all if the prey is unavailable.
- These are carnivores and feed on a wide variety of small mammals such as lemmings, meadow voles etc.
- They use a ‘wallop’ hunting method – swooping down and snatching prey with their strong talons.
- Conservation Status
- IUCN Red List: Vulnerable




